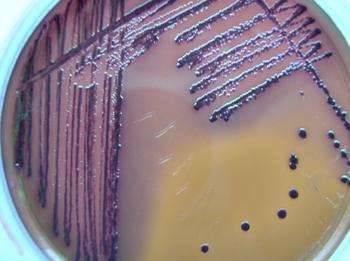
大肠杆菌

大肠杆菌是人和动物肠道中最著名的一种细菌 ,主要寄生于大肠内,约占肠道菌中的1%。是一种两端钝圆、能运动、无芽孢的革兰氏阴性短杆菌。大肠杆菌能合成维生素B和K,正常栖居条件下不致病;若进入胆囊 、膀胱等处可引起炎症。在水和食品中检出,可认为是被粪便污染的指标。
美国疾病控制和预防中心最近更新数据显示,包括得克萨斯、纽约、伊利诺伊、华盛顿、阿拉巴马等在内的15个州已报告27人感染大肠杆菌,超过1/3病患入院治疗,81%为21岁以下,最小的仅2岁。其中,两人因并发症——溶血性尿毒综合症而使病情恶化,导致肾功能衰竭。截至目前,还没有死亡报告。
据美联社9日报道,过去两周,该公司召回了1000万磅被污染的冷冻食品,只涉及佐治亚州分厂,保质期为2013年1月1日至2014年9月29日。公司发言人格拉姆(Dwight Gram)表示,估计市场上仍有大约300万磅疑遭污染的食品在出售,恐怕有30万磅已进入学校的营养午餐体系,主要包括冷冻披萨片和意大利辣味香肠披萨饼。
此次召回事件涉及的病原性大肠杆菌非常罕见,且很难识别,因此可能有更多人因此致病却并不自知。疾病控制和预防中心正与各州官员合作,被采访的18名病患都表示曾吃过冷冻食物,8人称吃过富裕农场品牌的产品。调查人员在纽约州和得克萨斯州两名患者家中已开封的富裕农场牌鸡肉薄饼和披萨中检验出了大肠杆菌。美国农业部食品安全检查服务局及美国食品药品管理局目前也在进行调查,以确定此次大肠杆菌爆发的源头。
马里兰州哈福德郡一所学校,已将涉及召回的产品给学生食用,提醒家长要密切观察孩子的身体状况。但格拉姆表示,学校提供的午餐可能更为安全,因为校方会更彻底地煮熟食物,从而杀死大肠杆菌。
纽约州西部甜蜜家园校区餐饮主管桑德拉(Sandra Cocca)10日称,他们严格检查了库存,已将为数不多的召回范围食品销毁,保证没有提供给学生食用。
文章由福冠堂新特药在线(www.fuguantang.com)整理发布